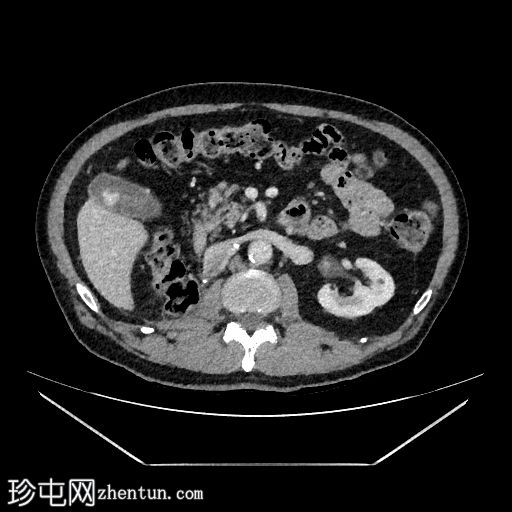
1.jpg

病例介绍
高危肾细胞癌分期CT检查。
患者资料
年龄:75岁
性别:男
CT
轴位增强扫描(C+)门静脉期
冠状位

骨窗
行CT检查以进行分期。已知肾细胞癌。已行右侧根治性肾切除术和左侧肾上腺切除术。胆囊内可见强化物质,提示胆囊底部血管受累。骨窗下胆囊内未见钙化灶。影像表现提示胆囊转移。
MRI
轴位
T2加权像

轴位T1加权像

同相位
轴位T1加权像

反相位
轴位T1加权像
增强扫描(C+)脂肪抑制

行MRI检查以明确病因。 MRI显示胆囊底部有一孤立性息肉样病变,突入胆囊内,大小约为21 mm x 17 mm。病变表面可见高T1信号,可能代表血液成分。病变早期增强扫描后强化程度较正常胆囊壁更为明显。
病例讨论
患者接受了胆囊切除术,组织病理学检查显示胆囊内无结石。胆囊内可见一息肉,大小为23 mm x 16 mm x 15 mm。
病理报告:
息肉检查显示为巢状肿瘤,由胞质透明、边界清晰、细胞核多形性的细胞组成。肿瘤细胞CAIX、PAX8和CD10染色阳性,符合转移性透明细胞型肾腺癌的特征。
诊断:转移性肾细胞癌。 |